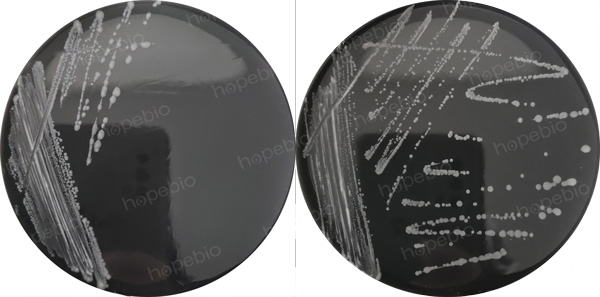
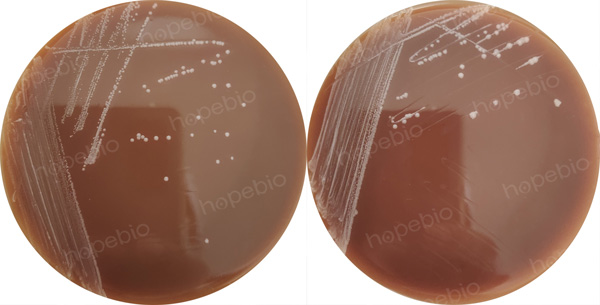
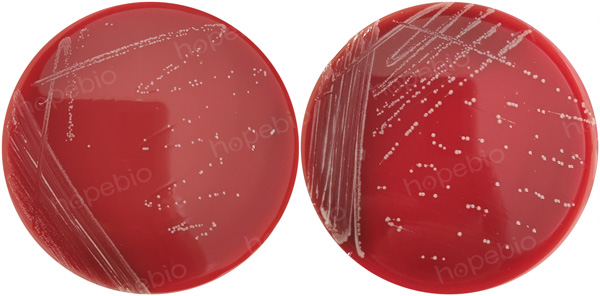

海博微信公众号
海博微信公众号
 海博天猫旗舰店
海博天猫旗舰店


 海博微信公众号
海博微信公众号
 海博天猫旗舰店
海博天猫旗舰店




一、空肠弯曲菌简介
空肠弯曲菌(Campylobacter jejuni)是弯曲菌属中的一个亚种,是引起急性腹泻的重要病原菌,许多国家报道,本菌从腹泻病例的分离率为5%~14%,从无症状人群的粪便标本中分离率小于1%,目前已证明为人畜共患病菌。
本菌为革兰氏阴性菌,多形态,螺旋性,弯曲杆状,有一个以上的螺旋并可长达8μm,也可出现S形或似飞翔的海鸥形;菌体一端或两端有单根鞭毛,长度约为菌体的2~3倍,有活泼的动力或不产生动力;超过48h的培养物以衰老的球菌状居多。
本菌属于微需氧菌,初次分离时需在含5%氧、85%氮和10%二氧化碳环境中,传代后能在10%二氧化碳环境中生长,在多氧和绝对无氧的环境中均不生长。培养适宜温度为25℃~43℃,培养最适温度为42℃,最适pH值7.2。对糖类既不发酵也不氧化,呼吸代谢无酸性或中性产物,生长不需血清,从氨基酸或三酸循环获得能量。
在布氏肉汤中生长呈均匀浑浊。在血琼脂上,初次分离出现两种菌落特征:第一型菌落不溶血、灰色、扁平、湿润、有光泽,看上去像水滴,边缘不规则,常沿划线蔓延生长;第二型菌落也不溶血,常呈分散凸起的单个菌落(直径1nm~2nm)边缘整齐、半透明、有光泽、中心稍浑,呈单个菌落生长。
在国内外标准(包括美国FDA、ISO、GB等标准)中,食品中空肠弯曲菌的检验通常是用Bolton肉汤进行选择性增菌培养,然后利用改良CCD琼脂和Skirrow血琼脂进行选择性分离,最后进行生化鉴定。
二、参考标准
《GB 4789.9-2014食品安全国家标准 食品微生物学检验 空肠弯曲菌检验》点击下载
三、检验程序
空肠弯曲菌检验程序见图1。

图1 空肠弯曲菌检验程序
四、检验方法及结果判断
4.1 样品处理
4.1.1 一般样品
取25g(mL)样品(水果、蔬菜、水产品为50g)加入盛有225mL的Bolton肉汤的有滤网的均质袋中(若为无滤网均质袋可使用无菌纱布过滤),用拍击式均质器均质1min~2min,经滤网或无菌纱布过滤,将滤过液进行培养。
4.1.2 整禽等样品
用200mL的0.1%的蛋白胨水中充分冲洗样品的内外部,并振荡2min~3min,经无菌纱布过滤至250mL离心管中,16000g离心15min后弃去上清,用10mL的0.1%蛋白胨水悬浮沉淀,吸取3mL于100mL的Bolton肉汤中进行培养。
4.1.3 贝类
取至少12个带壳样品,除去外壳后将所有内容物放到均质袋中,用拍击式均质器均质1min~2min,取25g样品至225mL的Bolton肉汤中(1:10稀释),充分震荡后再转移25mL于225mL的Bolton肉汤中(1:100稀释),将1:10和1:100稀释的Bolton肉汤同时进行培养。
4.1.4 蛋黄液或蛋浆
取25g(mL)样品于125mL的Bolton肉汤中并混匀(1:6稀释),再转移25mL于100mL的Bolton肉汤中并混匀(1:30稀释),同时将1:6和1:30稀释的Bolton肉汤进行培养。
4.1.5 鲜乳、冰淇淋、奶酪等
若为液体乳制品取50g;若为固体乳制品取50g加入盛有50mL的0.1%蛋白胨水的有滤网均质袋中,用拍击式均质器均质15s~30s,保留过滤液。必要时调整pH值至7.5±0.2,将液体乳制品或滤过液以20000g离心30min后弃去上清,用10mL的Bolton肉汤悬浮沉淀(尽量避免带入油层),再转移至90mL的Bolton肉汤进行培养。
4.1.6 需表面涂拭检测的样品
无菌棉签擦拭检测样品的表面(面积至少100cm2以上),将棉签头剪落到100mL的Bolton肉汤中进行培养。
4.1.7 水样
将4L的水(对于氯处理的水,在过滤前每升水中加入5mL 1mol/L硫代硫酸钠溶液)经0.45μm滤膜过滤,把滤膜浸没在100mL的Bolton肉汤中进行培养。
4.2 预增菌与增菌
在微需氧条件下,36℃±1℃培养4h,如条件允许配以100r/min的速度进行振荡。必要时测定增菌液的pH值并调整至7.4±0.2,42℃±1℃继续培养24h~48h。培养结果如图2所示。
Bolton肉汤原理:乳白蛋白水解物、动物组织酶解物提供碳、氮源;酵母浸膏提供各种维生素;氯化钠维持均衡的渗透压;丙酮酸钠和偏亚硫酸氢钠能中和培养基的有毒物质,也能增强培养基的空气耐受力;α-酮戊二酸提供生长因子,促进空肠弯曲菌的生长;碳酸钠提供空肠弯曲菌最有利的酸碱环境;头孢哌酮和多粘菌素B抑制革兰氏阴性菌的生长;万古霉素和三甲氧苄嘧啶抑制革兰氏阳性菌的生长;两性霉素B抑制酵母和真菌的生长。
Bolton肉汤用法:称取基础培养基27.6g,加入蒸馏水或去离子水1L,搅拌加热煮沸至完全溶解,分装三角瓶,121℃高压灭菌15min。待Bolton肉汤基础冷却至45℃左右,在无菌条件下,每100mL基础培养基加入5mL无菌裂解脱纤维羊或马血和1支Bolton肉汤添加剂,混匀,备用。
注:培养基高压灭菌后有一些小黑色颗粒。

图2 Bolton肉汤增菌培养结果
4.3 分离
将24h增菌液、48h增菌液及对应的1:50稀释液分别划线接种于Skirrow血琼脂与mCCDA平板上,微需氧条件下42℃±1℃培养24h~48h。培养结果分别如图4、图3所示。另外可选择使用空肠弯曲菌显色平板作为补充。
观察24h培养与48h培养的琼脂平板上的菌落形态,mCCDA平板上的可疑菌落通常为淡灰色,有金属光泽、潮湿、扁平,呈扩散生长的倾向。Skirrow血琼脂平板上的第一型可疑菌落为灰色、扁平、湿润有光泽,呈沿接种线向外扩散的倾向;第二型可疑菌落常呈分散凸起的单个菌落,边缘整齐、发亮。
空肠弯曲菌显色培养基上的可疑菌落按照说明进行判定。
mCCDA原理:肉浸液、动物组织酶解物、酪蛋白酶解物提供碳、氮源,维生素,生长因子;氯化钠维持均衡的渗透压;木炭具有解毒、收集二氧化碳和改变表面张力的作用;去氧胆酸钠为选择性抑菌剂;头孢哌酮可抑制普通肠道菌生长,两性霉素B抑制酵母和真菌生长,利福平可抑制非弯曲菌其他厌氧菌的生长。硫酸亚铁和丙酮酸钠有利于空肠弯曲菌的生长;琼脂是培养基的凝固剂。
mCCDA用法:称取本品51.5g,加入1L蒸馏水或去离子水中,搅拌加热煮沸至完全溶解,分装三角瓶,每瓶200mL,121℃高压灭菌15min。待基础培养基的冷却至45℃左右时,加入1支改良CCD琼脂添加剂(含头孢哌酮6.4mg、两性霉素B2mg和利福平2mg),混匀,倾入无菌平皿,备用。
|
|
|
空肠弯曲菌 CICC 22936 |
空肠弯曲菌 ATCC 33291 |
Skirrow琼脂原理:蛋白陈、胰蛋白陈、酵母浸膏提供碳、氮源,维生素,生长因子;氯化钠维持均衡的渗透压;丙酮酸钠、焦亚硫酸钠、硫酸亚铁有利于弯曲菌的生长。头孢哌酮可抑制革兰氏阴性细菌和部分革兰氏阳性菌的生长;两性霉素B抑制真菌生长;利福平可抑制非弯曲菌其他厌氧菌;琼脂是培养基的凝固剂。
Skirrow用法:称取基础培养基42.5g,加入蒸馏水或去离子水1L,搅拌加热煮沸至完全溶解,分装三角瓶,每瓶100mL,121℃高压灭菌15min。待基础培养基的冷却至45℃左右时,加入1mL过滤除菌的FBP溶液、1支改良Skirrow氏琼脂基础添加剂和无菌冻溶脱纤维羊血5mL,混匀,倾入无菌平皿。预先制备的平板未干燥时在室温放置不得超过4天或在4℃左右冷藏不得超过7天。
|
|
|
空肠弯曲菌 CICC 22936 |
空肠弯曲菌 ATCC 33291 |
图4 Skirrow琼脂培养结果
4.4 鉴定
4.4.1 弯曲菌属的鉴定
4.4.1.1 概述
挑取5个(如少于5个则全部挑取)或更多的可疑菌落接种到哥伦比亚血琼脂平板上,微需氧条件下42℃±1℃培养24h~48h,生长情况如图5所示。
|
|
|
空肠弯曲菌 CICC 22936 |
空肠弯曲菌 ATCC 33291 |
图5 哥伦比亚血琼脂平板微需氧条件下42℃±1℃培养结果
按照4.4.1.1~4.4.1.5进行鉴定,结果符合表1的可疑菌落确定为弯曲菌属。
表1 弯曲菌属的鉴定
|
项 目 |
弯曲菌属特性 |
|
形态观察 |
革兰氏阴性,菌体弯曲如小逗点状,两菌体的末端相接时呈S形、螺旋状或海鸥展翅状a |
|
动力观察 |
呈现螺旋状运动b |
|
氧化酶试验 |
阳性 |
|
微需氧条件下25℃±1℃生长试验 |
不生长 |
|
有氧条件下42℃±1℃生长试验 |
不生长 |
|
a有些菌株的形态不典型。b有些菌株的运动不明显。 |
|
4.4.1.2 形态观察
挑取可疑菌落进行革兰氏染色,镜检。结果如图6所示。

图6 革兰氏染色镜检结果
4.4.1.3 动力观察
挑取可疑菌落用1mL布氏肉汤悬浮,用相差显微镜观察运动状态。
4.4.1.4 氧化酶试验
用铂/铱接种环或玻璃棒挑取可疑菌落至氧化酶试剂润湿的滤纸上,如果在10s内出现紫红色、紫罗兰或深蓝色为阳性。结果如图7所示。

图7 氧化酶试验结果
4.4.1.5 微需氧条件下25℃±1℃生长试验
挑取可疑菌落,接种到哥伦比亚血琼脂平板上,微需氧条件下25℃±1℃培养44h±4h,观察细菌生长情况。空肠弯曲菌在该培养条件下不生长,培养结果如图8所示。
 |
|
|
空肠弯曲菌 CICC 22936 |
空肠弯曲菌 ATCC 33291 |
4.4.1.6 有氧条件下42℃±1℃生长试验
挑取可疑菌落,接种到哥伦比亚血琼脂平板上,有氧条件下42℃±1℃培养44h±4h,观察细菌生长情况。空肠弯曲菌在该培养条件下不生长,培养结果如图9所示。
 |
|
|
空肠弯曲菌 CICC 22936 |
空肠弯曲菌 ATCC 33291 |
图9 哥伦比亚血琼脂平板有氧条件下42℃±1℃培养结果
4.4.2 空肠弯曲菌的鉴定
4.4.2.1 过氧化氢酶试验
挑取菌落,加到干净玻片上的3%过氧化氢溶液中,如果在30s内出现气泡则判定结果为阳性。结果如图10所示。
 |
|
|
大肠埃希氏菌 ATCC 25922 |
空肠弯曲菌 ATCC 33291 |
图10 过氧化氢酶试验结果
挑取菌落,加到盛有0.4mL的1%马尿酸钠的试管中制成菌悬液。混合均匀后在36℃±1℃水浴中温育2h或36℃±1℃培养箱中温育4h。沿着试管壁缓缓加入0.2mL的茚三酮溶液,不要振荡,在36℃±1℃的水浴或培养箱中再温育10min后判读结果。若出现深紫色则为阳性;若出现淡紫色或没有颜色变化则为阴性。结果如图11所示。

挑取菌落至吲哚乙酸酯纸片上,再滴加一滴灭菌水。如果吲哚乙酸酯水解,则在5min~10min内出现深蓝色;若无颜色变化则表示没有发生水解。不同细菌在吲哚醋酸酯纸片上的生化反应现象如图12所示。

图12 吲哚乙酸酯水解试验结果
空肠弯曲菌的鉴定结果见表2。
表2 空肠弯曲菌的鉴定特征
|
|
空肠弯曲菌 (C. jejuni) |
结肠弯曲菌 (C. coli) |
海鸥弯曲菌 (C. lari) |
乌普萨拉弯曲菌 (C. upsaliensis) |
|
过氧化氢酶试验 |
+ |
+ |
+ |
-或微弱 |
|
马尿酸盐水解试验 |
+ |
- |
- |
- |
|
吲哚乙酸酯水解试验 |
+ |
+ |
- |
+ |
|
注:+表示阳性;-表示阴性。 |
||||
4.4.2.4 替代试验
对于确定为弯曲菌属的菌落,可使用生化鉴定试剂盒或生化鉴定卡代替4.4.2.1~4.4.2.3进行鉴定。
4.5 结果报告
综合以上试验结果,报告检样单位中检出或未检出空肠弯曲菌。
相关标准:
注:本文属海博生物原创,未经允许不得转载。
下一篇:蜡样芽孢杆菌检验方法及结果判断



